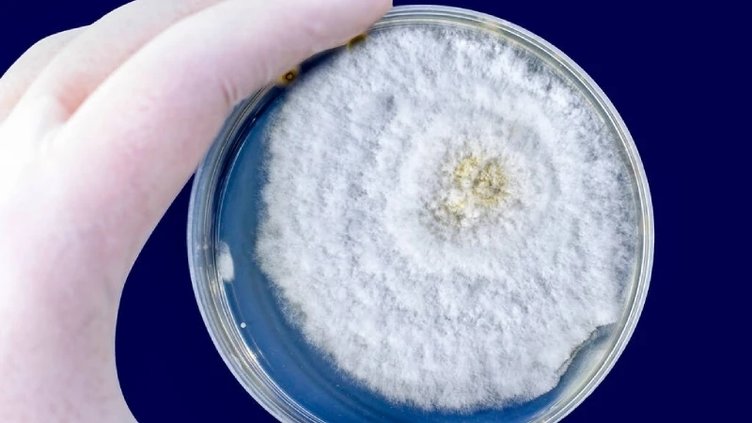
Enfeksiyonun beyne sıçramasına engel olmak amacıyla hastaların gözleri çıkarıldı! Kara mantar salgını nedir?

Hindistan'da korkunç bir hastalık olan "kara mantar" salgını ortaya çıktı. İlk olarak Hindistan'da görülen hastalık Mısır, Irak ve Meksika'da da ortaya çıktı. Peki kara mantar (mukormikoz) hastalığı nedir, belirtileri nelerdir?


"Kara mantar" olarak da bilinen nadir ve ölümcül durum olan mukromikoz, zayıf bir bağışıklık sistemine sahip insanları öldürebilen, mukromisetler olarak bilinen ve doğal olarak mevcut küflerden kaynaklanıyor.

KARA MANTAR (MUKORMİKOZ) NEDİR?
Kara mantar (Mukormikoz) çok nadir görülen bir enfeksiyondur. Genellikle toprakta, bitkilerde, gübrede ve çürüyen meyve ve sebzelerde bulunan mucor küfüne maruz kalmaktan kaynaklanır. Beyni, sinüsleri ve akciğerleri etkileyen kara mantar, kanser hastaları veya HIV/AIDS'li kişiler gibi diyabetik veya bağışıklık sistemi ciddi şekilde zayıflamış kişilerde tehlikeli olabilir.
KARA MANTARIN NEDENİ STEROİDLER Mİ?
Doktorlar, salgının şiddetli Covid-19 tedavisinde kullanılan steroidlerden kaynaklandığına inanıyor çünkü ilaçlar bağışıklığı azaltıyor ve kandaki şeker seviyelerini yükseltiyor.
KARA MANTAR (MUKORMİKOZ) BELİRTİLERİ NELERDİR?
Yüzde şişlik ve siyah lezyonlar hastalığın başlıca belirtileri arasında yer alıyor. Bazı kaynaklarda ise göz kararması veya renk değişikliği, bulanık veya çift görme, göğüs ağrısının da belirti olabileceği söyleniyor.

KARA MANTAR (MUKORMİKOZ) TEDAVİSİ NEDİR?
Hızla yayılan ölümcül bir mantar hastalığı olan kara mantar enfeksiyonu, öncelikli olarak şüpheler doğrultusunda hastanede kontrol altına alınması gerekir. Tanı konduktan hemen sonra tedaviye başlanmalıdır. Erken teşhis oldukça önemlidir. Öncelikle altta yatan hastalığın kontrol altına alınması önemlidir. Cerrahi operasyonla hastalıktan kurtulma ihtimali yüksektir.

KARA MANTAR HASTALIĞI NASIL BULAŞIR?
Kara mantar insandan insana bulaşmıyor ancak havadaki veya ortamdaki mantar sporları ile bu küf mantarı yayılabiliyor. Uzmanlar, insan vücudunda birçok bakteri ve mantar olduğunu fakat bağışıklı sistemi sayesinde bunların kontrol altında tutulduğunu söylüyor.